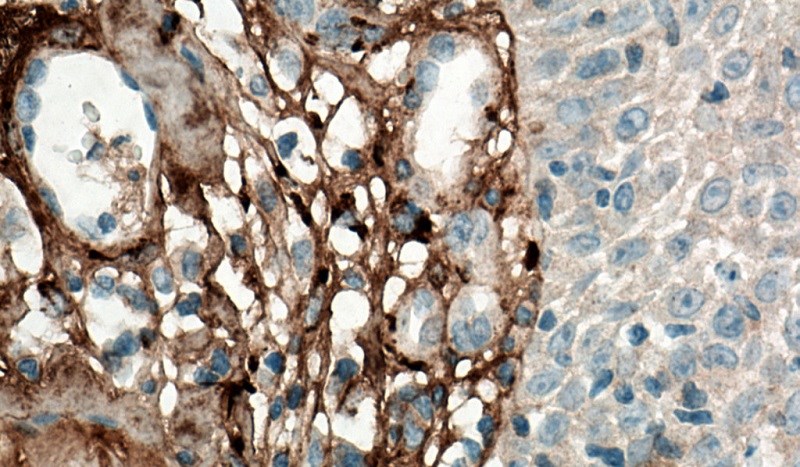
Collagen loại 3

Collagen là một thuật ngữ thường hay nhắc đến trong lĩnh vực làm đẹp nhưng bạn đã thực sự hiểu rõ về các loại collagen hiện nay? Nếu chưa, chần chờ gì mà không vào ngay chuyên mục Mẹo vào bếp để tìm hiểu những thông tin về các loại collagen trong cơ thể và theo chế phẩm cũng như collagen loại nào thực sự tốt?
Trong cơ thể, người ta tìm thấy có ít nhất 16 loại collagen được phân bổ đều khắp cơ thể với đặc tính và chức năng khác nhau. Cụ thể, có thể phân thành 4 loại chính như sau:
Nhóm collagen loại này được tạo thành từ những sợi dày đặc, chiếm gần 90% collagen trong cơ thể. Vì thế, chúng được tìm thấy ở cấu trúc da, gân, mô liên kết, sụn sợi, xương và răng.

Nhóm collagen loại 2 được tạo ra từ những sợi mô lỏng lẻo hơn, có tác dụng đệm cho các khớp nên được tìm thấy ở phần sụn.

Nhóm collagen loại 3 có khả năng hỗ trợ cấu trúc của các cơ, bộ phận cơ quan và động mạch trong cơ thể.
Nhóm collagen loại 4 đảm nhiệm chức năng lọc và duy trì độ đàn hồi nên được tìm thấy trong các lớp da của cơ thể.

Như vậy, bạn có thể thấy collagen có mặt hầu hết các bộ phận trong cơ thể, chứ không chỉ riêng gì ở bộ phận da mà bạn từng biết trước đây.
Vì thế, khi con người càng lớn tuổi thì việc sản xuất collagen càng trở nên ít hơn và hay gặp phải về nhiều vấn đề liên quan đến collagen như da chảy xệ, mất độ đàn hồi, xuất hiện nếp nhăn,… hay sụn trở nên yếu hơn.

Việc bổ sung collagen bên ngoài rất cần thiết cho những ai bị thiếu hụt collagen để tránh gặp phải nhiều vấn đề liên quan đến sức khỏe. Do đó, nếu theo chế phẩm thì có 4 loại collagen mà bạn có thể cân nhắc khi sử dụng, như:
Viên uống collagen được tạo hình giống con nhộng, kích thước khá to với hàm lượng được tính toán kỹ trong mỗi viên. Tùy theo nhà sản xuất mà mỗi viên collagen sẽ mang lại hiệu quả cho người dùng khác nhau, thậm chí còn phụ thuộc vào cơ địa của người uống.

Thay vì uống viên nang, thì các nhà sản xuất mang đến cho người tiêu dùng collagen dạng nước rất tiện lợi khi sử dụng. Hầu hết, nước collagen được chứa trong chai, lọ làm bằng thủy tinh với hàm lượng cũng được tính toán kỹ.
Đây là chế phẩm collagen có hương vị dễ uống, dễ nuốt và dễ tiêu hóa cho người dùng.

Bột collagen thoạt nhìn giống với bột gelatin (dùng cho làm bánh pudding), nhưng thực ra đây là một trong những chế phẩm của collagen có dược tính như viên nang và nước collagen vậy.
Bột collagen được đựng trong gói nhỏ với hàm lượng được khuyến nghị từ nhà sản xuất. Khi uống, bạn cần phải thao tác thêm một công đoạn, đó là pha với lượng nước (theo hướng dẫn).

Khác với những loại trên, gel collagen được sử dụng như kem dưỡng da bằng cách thoa trực tiếp lên bề mặt của da. Lúc này, các dưỡng chất từ gel sẽ thấm sâu vào bên trong da như bạn sử dụng các sản phẩm chăm sóc da.

Thực tế, điều này còn tùy thuộc vào nhu cầu sử dụng và khả năng chi tiêu của bạn khi chọn dùng các chế phẩm collagen.
Nhìn chung, collagen dạng nước có khả năng hấp thụ nhanh chóng vào bên trong cơ thể hơn so với các loại khác. Đồng thời, loại này cũng tiện lợi cho việc sử dụng vì bạn chỉ cần mở nắp chai và uống trực tiếp như uống nước tăng lực vậy.
Trong khi đó, collagen dạng viên và dạng bột thì bạn cần phải dùng thêm nước bên ngoài. Hơn nữa, tốc độ thẩm thấu của dưỡng chất collagen vào cơ thể chậm hơn so với việc dùng collagen dạng nước.

Đối với collagen dạng gel được sử dụng như các sản phẩm chăm sóc da nên cũng có ưu và nhược điểm riêng.
Chẳng hạn, tốc độ thẩm thẩu của gel collagen còn tùy thuộc cấu trúc da của mỗi người và một số yếu tố khác. Có thể nói, dưỡng chất hấp thụ của gel collagen sẽ không bằng so với việc dùng collagen dạng nước, dạng viên và dạng bột để uống trực tiếp vào bên trong cơ thể.
Tuy nhiên, bạn có thể cân nhắc việc phối hợp giữa collagen dạng gel với collagen dạng nước, dạng bột hoặc dạng viên. Cách làm này sẽ giúp cơ thể hấp thụ tối ưu các dưỡng chất collagen từ trong và ngoài cơ thể một cách hiệu quả, hỗ trợ bạn cải thiện sức khỏe đáng kể, nhất là da và xương khớp.

Với chia sẻ vừa rồi, hy vọng bạn đã biết thêm về các loại collagen trong cơ thể và theo chế phẩm cũng như sử dụng collagen loại nào là tốt cho sức khỏe rồi nhé! Chúc bạn có thật nhiều sức khỏe với thông tin hữu ích cùng Điện máy XANH.
*Tổng hợp và tham khảo thông tin từ Healthline.
↑
Đang xử lý... Vui lòng chờ trong giây lát.